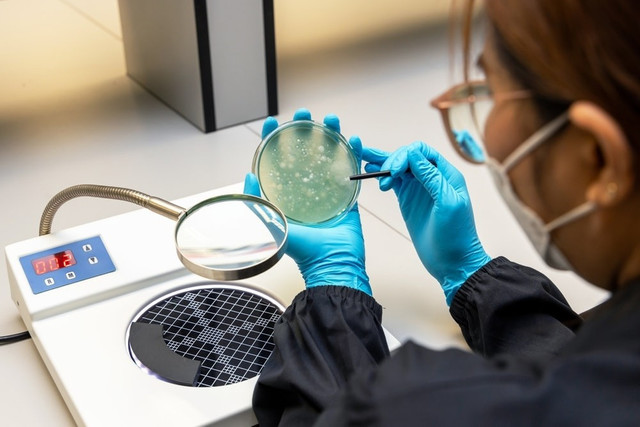
İyileşme umudu en büyük risk oldu! 40 milyon kişi ölebilir - Resim : 3

İyileşme umudu en büyük risk oldu! 40 milyon kişi ölebilir
Gereksiz ilaç ve antibiyotik kullanımına ilişkin yapılan son araştırma çarpıcı gerçekleri ilk kez gözler önüne serdi. Uzmanlara göre sadece antibiyotik direnci nedeniyle 2050 yılına kadar 40 milyon insan ölebilir.
Doktora gittiğimizde teşhis ve tedaviden çok daha fazla ilgimizi çeken konunun reçete olması hiç de şaşırtıcı değil. Çünkü artan yaş ortalaması nedeniyle ‘bir kez daha doktora gitmemek’, ‘bir kez daha uzun kuyrukta beklememek’, ‘bir kez daha tedirginlik yaşamamak’... için (liste uzayıp gider) kesin çözüm arıyoruz.
Yani doktorumuzdan ihtiyacımızdan daha fazla ilaç yazmasını istiyor ya da tüm bakterilerimizin hızlıca ölmesi için ille de antibiyotik diyoruz.
Bugün yaygın olarak reçetelendirilen eritromisin isimli antibiyotiğe dirençli Streptococcus bakterileri, boğaz enfeksiyonundan zatürreye kadar çeşitli enfeksiyonlara neden olabiliyor.
Pazartesi günü dünyanın en prestijli tıp dergilerinden biri olan The Lancet'te yayınlanan bir araştırmaya göre, 2050 yılına kadar 40 milyon insan antibiyotik dirençli enfeksiyonlardan ölebilir.
Bu şu anlama geliyor; ne kadar çok antibiyotik kullanırsak, vücudumuzdaki zararlı bakteriler de kullandığımız antibiyotiğe karşı direnç geliştiriyor. Bu da bir sonraki hastalığınızda aynı ilacın ya daha az etkili olması ya da hiç etkili olmaması anlamına geliyor.
Biz kabından çıkarıp ağzımıza attığımız pek çok ilacın prospektüsünü bile okumazken, vücudumuzda bizi hastalandıran bakteriler kullandığımız ilaca karşı 'Nasıl direnç oluşturabiliriz?' sorusunun peşine düşüyor.

'BU BÜYÜK VE KALICI BİR SORUN'
Çalışmanın yazarları, 2022'den 2050'ye kadar antimikrobiyal direnç nedeniyle ölümlerde yaklaşık %70'lik bir artış öngörüyor. Ölüm artış oranı en yüksek risk grubu ise yaşlılar. AMR olarak da bilinen bu tür direnç, bakteri ve mantar gibi mikropların mevcut ilaçlarla öldürülmesini zorlaştıracak şekilde evrimleşmesiyle ortaya çıkıyor. Washington Üniversitesi Sağlık Ölçümleri ve Değerlendirme Enstitüsü müdürü ve çalışmanın kıdemli yazarı Christopher J. L. Murray, "Bu büyük bir sorun ve kalıcı olacak" diyor.
Araştırmacılar, antimikrobiyal direnci onlarca yıldır bir halk sağlığı endişesi olarak nitelendirdiler, ancak Küresel Antimikrobiyal Direnç Araştırma Projesi'nin bir parçası olarak büyük bir araştırmacı ekibi tarafından yürütülen bu çalışma, dünya çapında ve zaman içinde AMR eğilimlerini analiz eden ilk analiz.
520 MİLYON ADET VERİ İNCELENDİ
Dünya Sağlık Örgütü, bu tür ilaca karşı direnç tehdidinin yalnızca yaygın enfeksiyonların tedavisini zorlaştırmakla kalmayıp, kemoterapi ve sezaryen gibi tıbbi müdahaleleri daha riskli hale getirdiğini söylüyor. Çünkü bu tip tedavi ya da cerrahi uygulamalardan sonra insan vücudu mikroba daha açık hale geldiği için olası enfeksiyonların önünde geçmek adına daha geniş kapsamlı ilaçlar tercih ediliyor. Çalışmada 204 ülkeden hastane taburcu kayıtları, sigorta talepleri ve ölüm belgeleri dahil olmak üzere 520 milyon veri seti incelendi.

31 YILDA 1 MİLYON ÖLÜM
Çalışmada 204 ülkeden hastane taburcu kayıtları, sigorta talepleri ve ölüm belgeleri dahil olmak üzere 520 milyon veri seti incelendi. İstatistiksel modellemeyi kullanan yazarlar, 1990 ile 2021 yılları arasında her yıl antimikrobiyal dirençle ilgili bir milyondan fazla ölümün gerçekleştiğini buldu. Araştırmacılara göre o zamandan beri AMR ölümleri aşırı arttı ve artış hızı daha da artacak.
Çalışmanın baş yazarı ve UCLA'da klinik tıp yardımcı doçenti olan Kevin Ikuta, önümüzdeki çeyrek yüzyılda yani 2050'ye kadar tahminen 40 milyon kişi bu nedenle ölecek. Bu da her dakika yaklaşık üç kişinin ölmesi anlamına geliyor. Bulgular ayrıca yükün eşit olarak dağıtılmadığını da gösteriyor. 1990 ile 2021 yılları arasında beş yaş ve altı çocuklarda AMR ölümlerinde %50'den fazla bir düşüş görülürken, 70 yaş ve üzeri yaşlılarda %80'den fazla bir artış görüldü.
ÇOCUKLAR DAHA GÜÇLÜ
Yazarlar, çocuklarda bu tür ölümlerin azalmaya devam edeceğini, 2050'ye kadar yarı yarıya azalacağını, ancak aynı dönemde yaşlılarda iki katına çıkacağını öngörüyor. Araştırmacılar, son 30 yılda gençler arasında antimikrobiyal dirençle ilgili ölümlerdeki azalma ve yaşlılar arasında bu tür ölümlerdeki artışın birbirini dengelediğini vurguluyor. Ancak, küresel nüfus yaşlandıkça ve enfeksiyona karşı daha savunmasız hale geldikçe, yaşlılar arasındaki AMR ölümleri yakında diğer yaş gruplarındakileri geride bırakabilir ve gelecekteki AMR ölümlerinin sayısını önemli ölçüde artırabilir.
Ayrıca, çalışmada tahmin edilen 11,8 milyon ölümün (tahmini 40 milyon ölümün yaklaşık %30'u) Güney Asya'da olacağı belirtildi. Yazarlar, Sahra Altı Afrika'daki bölgelerde de çok sayıda AMR ölümü görüleceğini öngörüyor. Doktor Ikuta şu bilgileri veriyor:
Antibiyotiklerin giderek daha fazla veya yanlış kullanıldığını görüyoruz, bu da zaman geçtikçe bakterilerin daha dirençli hale gelmesi için daha fazla baskı oluşturuyor. Sonuç olarak, antibiyotiğe erişim kolaylaşırken, aşırı ilaç kullanımını kontrol altına almak için daha ciddi tedbirler alınması gerekiyor.
YAN ETKİLER ANLATILMALI
Harvard Tıp Fakültesi'nde birincil bakım doktoru ve tıp doçenti olan Ishani Ganguli, ihtiyaç duyulmadığında antibiyotiği reçeteye yazmaktan kaçınılması gerektiğini vurgulayan bir diğer isim. Ganguli durumu şöyle ayrıntılandırıyor:
Bir kopukluk varsa ve hastanız gerçekten bir antibiyotik istiyorsa... Ve ben de bunun bu durumda hastama yardımcı olacağını düşünmüyorsam, antibiyotiğin ona ishal ve mantar enfeksiyonları gibi yan etkilere neden olacağını anlatma yoluna giderim.
STRATEJİ: ANTİBİYOTİKLERİN GELİŞTİRİLMESİ
Ganguli, bir klinisyen olarak görevinin, antibiyotiklerin uygun olmadığı durumlarda hastaları bilgilendirmek ve soğuk algınlığı durumunda tuzlu su gargaraları ve nemlendiriciler gibi diğer tedavi seçeneklerini sunmak olduğunu vurguluyor.
Yazarlar antibiyotik yönetiminin yanı sıra temiz suya ve aşıya erişimin artırılması ve AMR'den kaynaklanan ölümlerin sayısını azaltmak için yeni antibiyotiklerin geliştirilmesi gibi enfeksiyon önleme stratejilerini savunuyorlar.